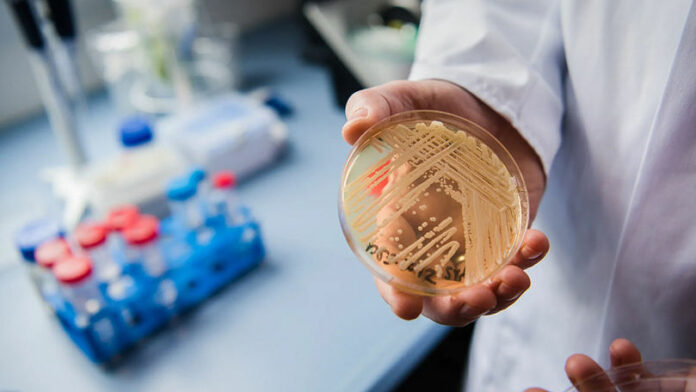
c7a8c0c779e1511f0b24ae4e313244da

O infecție fungică periculoasă, rezistentă la medicamente, se răspândește rapid în spitalele din întreaga Europă, a avertizat principala autoritate europeană în domeniul sănătății, scrie stiri.md cu trimitere la point.md.
Agenția a menționat: „Numărul de cazuri crește, focarele devin mai ample, iar mai multe țări raportează transmiterea continuă a infecției la nivel local.”
C. auris, cunoscut anterior ca Candida auris, se răspândește de obicei în instituțiile medicale și afectează în principal persoanele aflate deja în stare critică. Ciuperca poate provoca infecții grave ale sângelui, creierului și măduvei spinării, oaselor și urechilor, precum și ale sistemelor respirator și urinar. Aproape 60% dintre persoanele infectate cu C. auris mor în termen de 90 de zile.
Ciuperca a dezvoltat rezistență la majoritatea medicamentelor antifungice, ceea ce face tratamentul extrem de dificil.
De asemenea, poate supraviețui mult timp pe diverse suprafețe și echipamente medicale și este rezistentă la majoritatea dezinfectanților. În Marea Britanie, în urma recoltării de probe în spitalele din întreaga țară, urme ale ciupercii au fost descoperite pe calorifere, pervazuri, chiuvete și echipamente medicale — termometre, tensiometre și stetoscoape.
Cel puțin 18 țări europene au raportat cazuri de infecție în ultimul deceniu, cele mai multe fiind înregistrate în Spania, Grecia, Italia, România și Germania. Primul focar de C. auris în UE a fost înregistrat într-un spital din Valencia în 2016, unde inițial au fost identificate patru cazuri printre pacienții secției de terapie intensivă, iar în câteva luni numărul acestora a crescut la 140 în aceeași unitate.